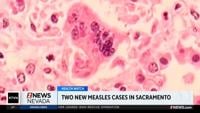

Health officials say two more children have contracted measles in Sacramento County.
From
To
The Springs Fire in Riverside County started yesterday.
The new report shows U.S. employers added 178,000 jobs last month.
Among the changes, renters now need to be at least 25 years old.
Prices continue skyrocketing in northern Nevada and nationwide due to the war in Iran.
Two pilots were killed in the crash.
The latest deluge pouring down onto a major highway in Maui. The cost of the damage could top a billion dollars.
Energy shortages are hitting countries across Asia, gas station closures and sparks protests.
This comes as Israel is calling on the international community to join in the war against Iran.
The speedway celebrated opening day Sunday.